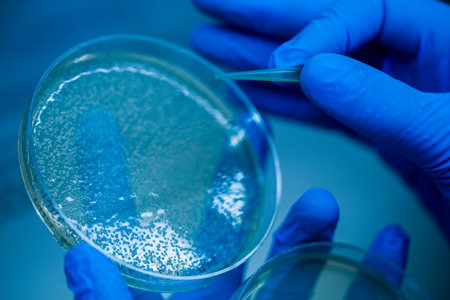
Production line pharmaceutical industry. Manufacturing of drugs and medications, pharmaceuticals. Technician, scientist works in a scientific laboratoryの写真素材

写真素材 - Production line pharmaceutical industry. Manufacturing of drugs and medications, pharmaceuticals. Technician, scientist works in a scientific laboratory
作品情報
Production line pharmaceutical industry. Manufacturing of drugs and medications, pharmaceuticals. Technician, scientist works in a scientific laboratory
- ID:291225545
- 作品種別:写真
- 作者名:bitenka
キーワード
- adult
- analysis
- analyzing
- biochemistry
- biotechnology
- business
- chemistry
- clinic
- development
- doctor
- equipment
- evil
- factory
- female
- hand
- health
- health care
- healthcare
- hospital
- human hand
- industry
- lab
- laboratory
- man
- manufacturing
- medical
- medicine
- microbiology
- people
- pharma
- pharmaceutical
- pharmacological
- prevention
- process
- production
- professional
- quality control
- research
- researcher
- science
- scientist
- study
- technician
- technology
- test tube
- vaccine
- virus
- work
- working
類似作品
Modern laborato...
Production of d...
Modern conveyor...
Bright, two-ton...
A clean and org...
A sleek robotic...
Production of d...
A sleek, high-t...
pharmaceutical ...
A healthcare ex...
pharmaceutical ...
Drug Production...
Red capsules mo...
Production line...
Vials of yellow...
Vials with drug...
scientist worki...
close look, lin...
Close-up Many w...
Production line...
Automatic machi...
Medical bottles...
Drinking water ...
Modern conveyor...
Close-up Many w...
medical bottles...
Tablets and a l...
BEIJING, CHINA ...
Vibrant blue an...
Red and yellow ...
BEIJING, CHINA ...
Hygiene worker ...
Blur background...
A skilled speci...
detail of pharm...
Concept food in...
Ampules With Me...
Automatic machi...
Vaccine vials w...
BEIJING, CHINA ...
Vials with drug...
Team members in...
close picture o...
pharmacy medici...
Blue capsule me...
Glass vials wit...
Small bottles g...
Blurred of scie...
A focused techn...